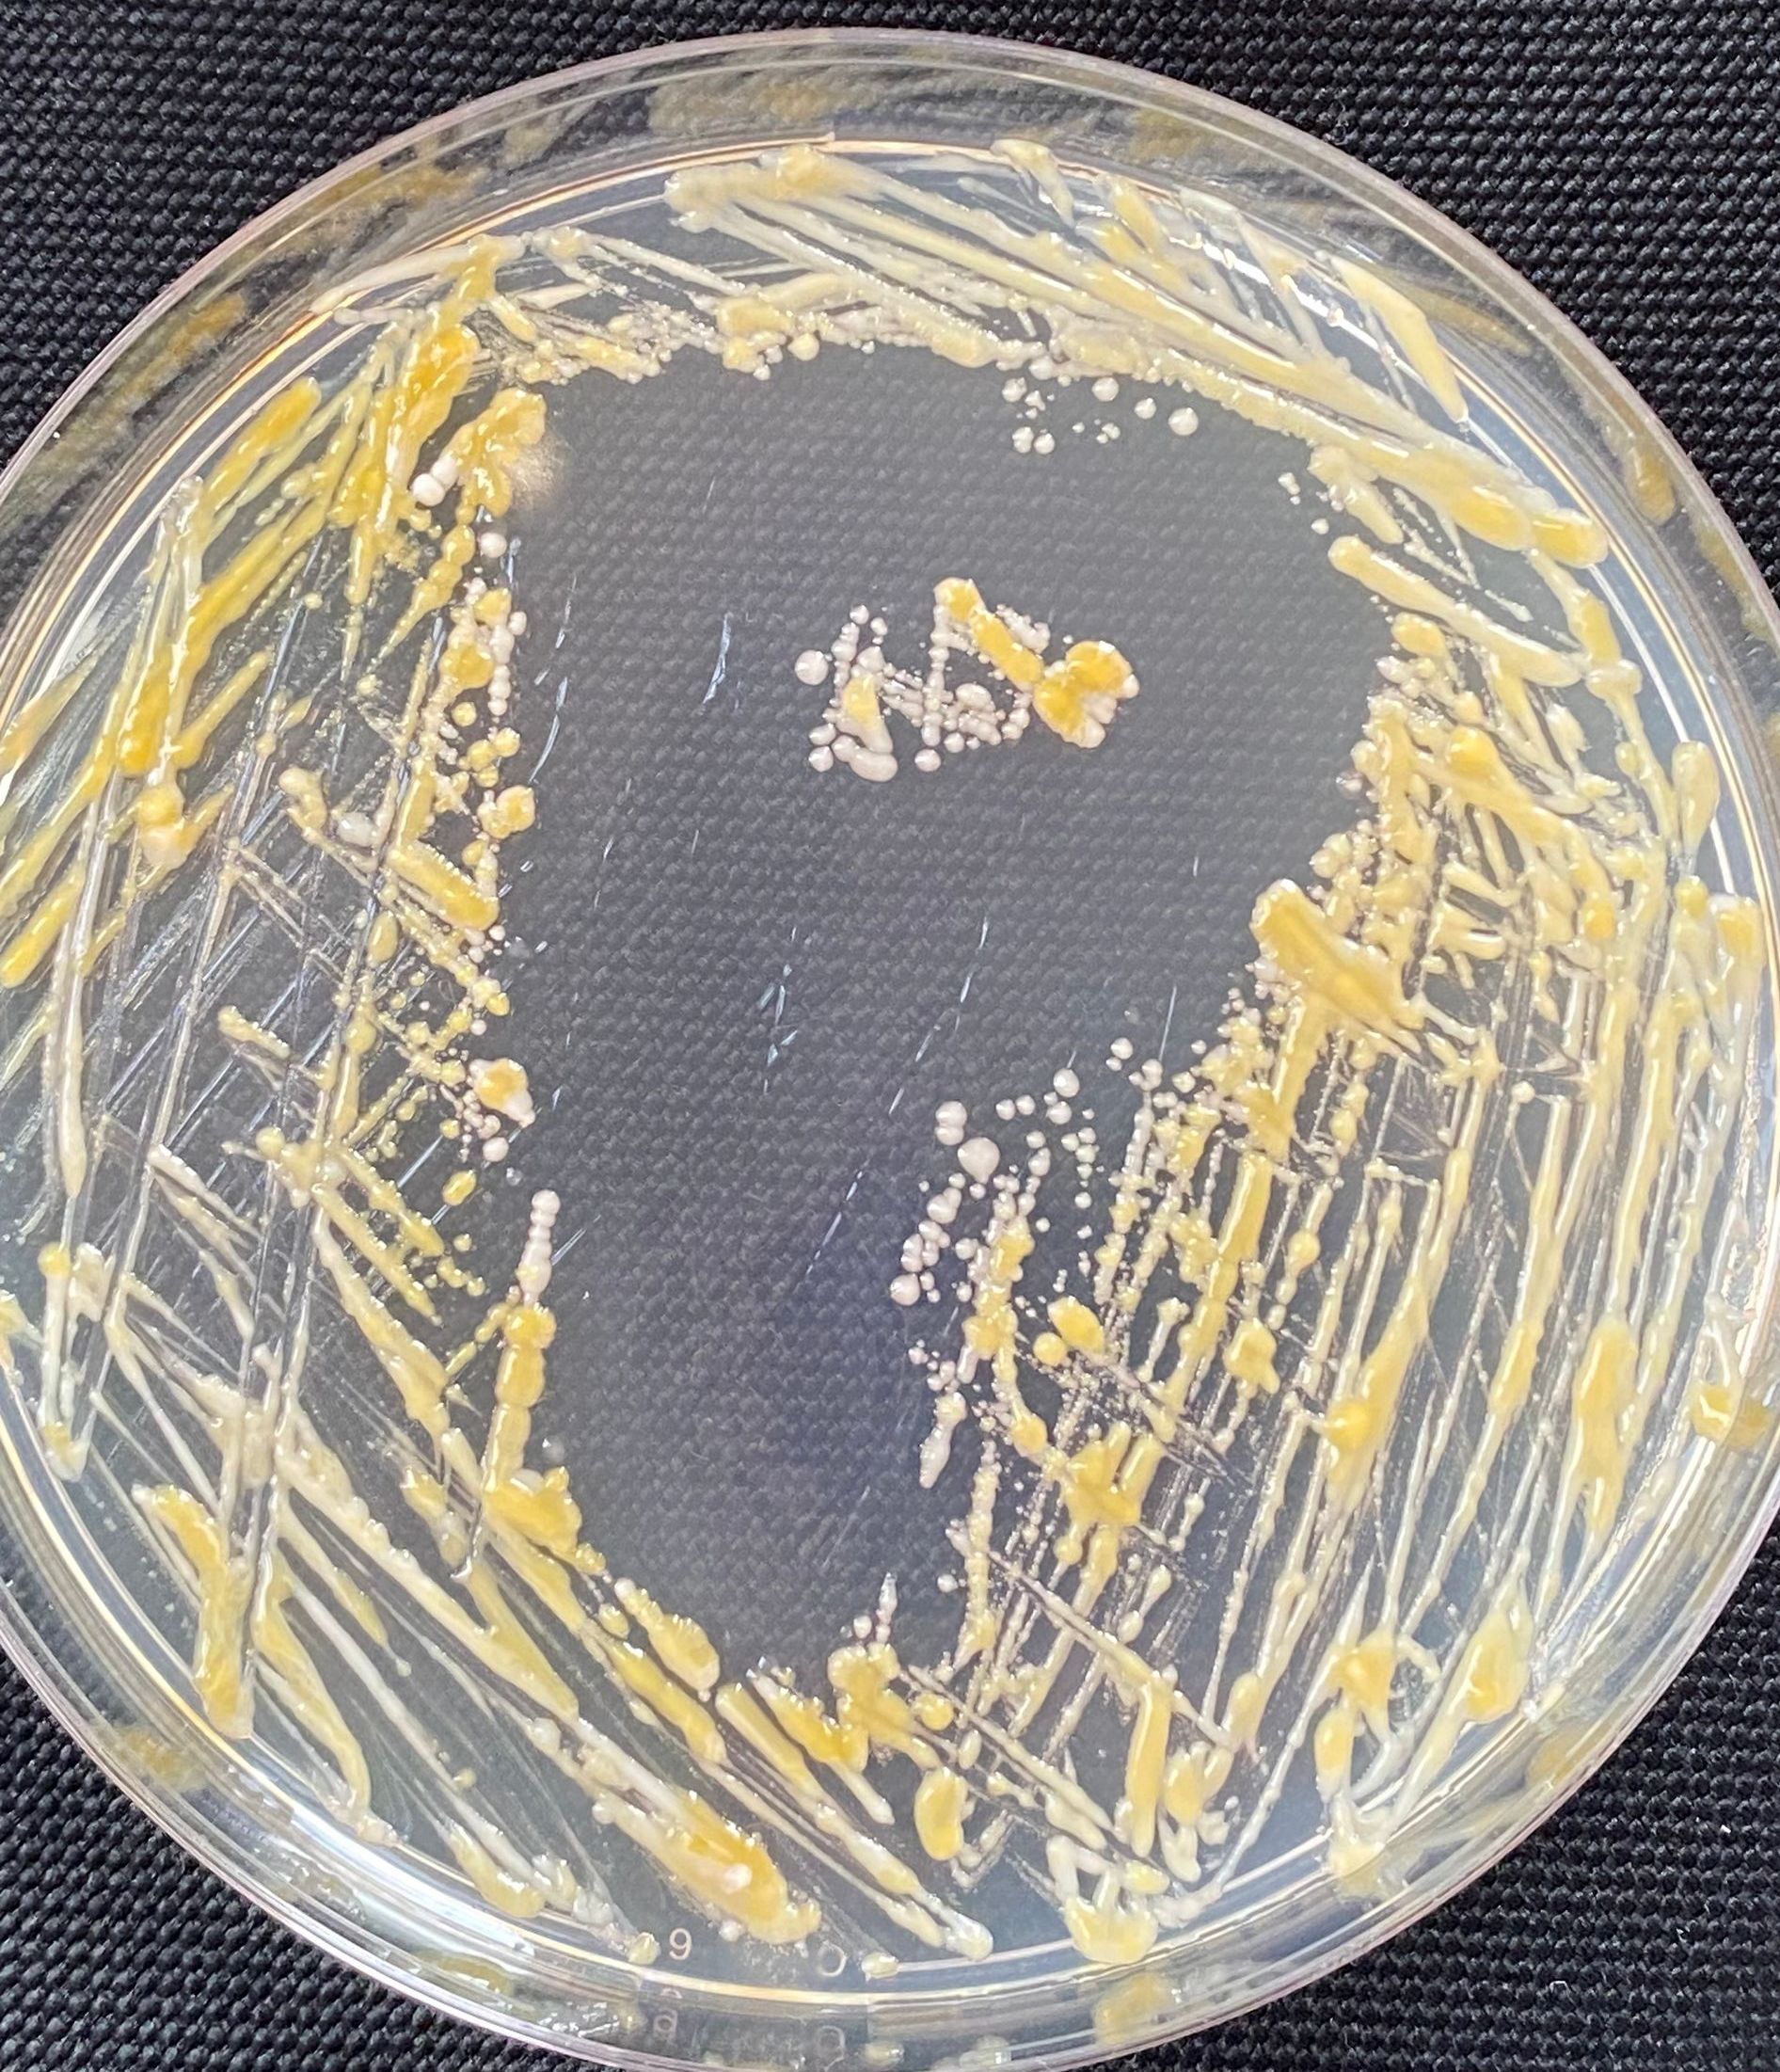

Atmosphärisches Kaltplasma
Was ist Kaltplasma?
Neben den drei Aggregatzuständen fest, flüssig und gasförmig wird das physikalische Plasma auch als "vierter Aggregatzustand" bezeichnet. Durch Energiezufuhr geht Gas (in diesem Fall die Raumluft) in diesen Zustand über. Dabei entstehen therapeutisch nutzbare reaktive Moleküle wie atomarer Sauerstoff, Superoxidradikale, Hydroxylradikale und Stickoxide.
Natürlicherweise entsteht atmosphärisches Plasma z.B. bei Gewitter.
Näheres auf
www.plasma-one.de
Wirkt das wirklich??
Das haben wir uns natürlich vor Einführung der Methode auch gefragt und für mehrere Monate verschiedene Testgeräte genutzt. Das hat uns überzeugt.
Ich habe außerdem in meinem Labor resistente Bakterien auf eine Kulturplatte geimpft und mit dem Plasmagerät ein "P" auf die Platte geschrieben. Nach einigen Tagen konnte man beobachten, wie die Bakterien gut anwachsen - allerdings nur dort, wo die Kulturplatte nicht mit dem Plasmagerät behandelt wurde. Im Buchstaben "P" sind keine lebenden Bakterien mehr übrig - die Behandlung mit Kaltplasma über 2 Minuten hat sie zuverlässig abgetötet.
Die Behandlung
Atmosphärisches Kaltplasma wirkt gegen Bakterien (auch gegen multiresistente Keime), Viren und Pilze und hilft so bei der Heilung chronischer Wunden, Herpes oder Warzen. Auch die Durchblutung wird durch diese Therapie verbessert.
Die Behandlung ist schmerzfrei und dauert nur wenige Minuten.
Die Plasmasonde wird im Abstand von 1-2 mm über die Haut geführt, dadurch entsteht ein Lichtbogen, der Keime zu 99,9 % abtötet, aber die menschlichen Zellen nicht schädigt.
Näheres auf
www.plasma-one.de
Die Kosten für die Behandlung werden von privaten Kassen im Allgemeinen übernommen. Es läuft aktuell eine Prüfung im Gemeinsamen Bundesausschuss zur Übernahme der Leistung in den Katalog der gesetzlichen Krankenkassen. Bis diese die Kosten übernehmen, müssen Patienten die Leistung als IgeLeistung in Anspruch nehmen. Eine Sitzung kostet als Selbstzahlerleistung 40 Euro, fünf Sitzungen 160 Euro.